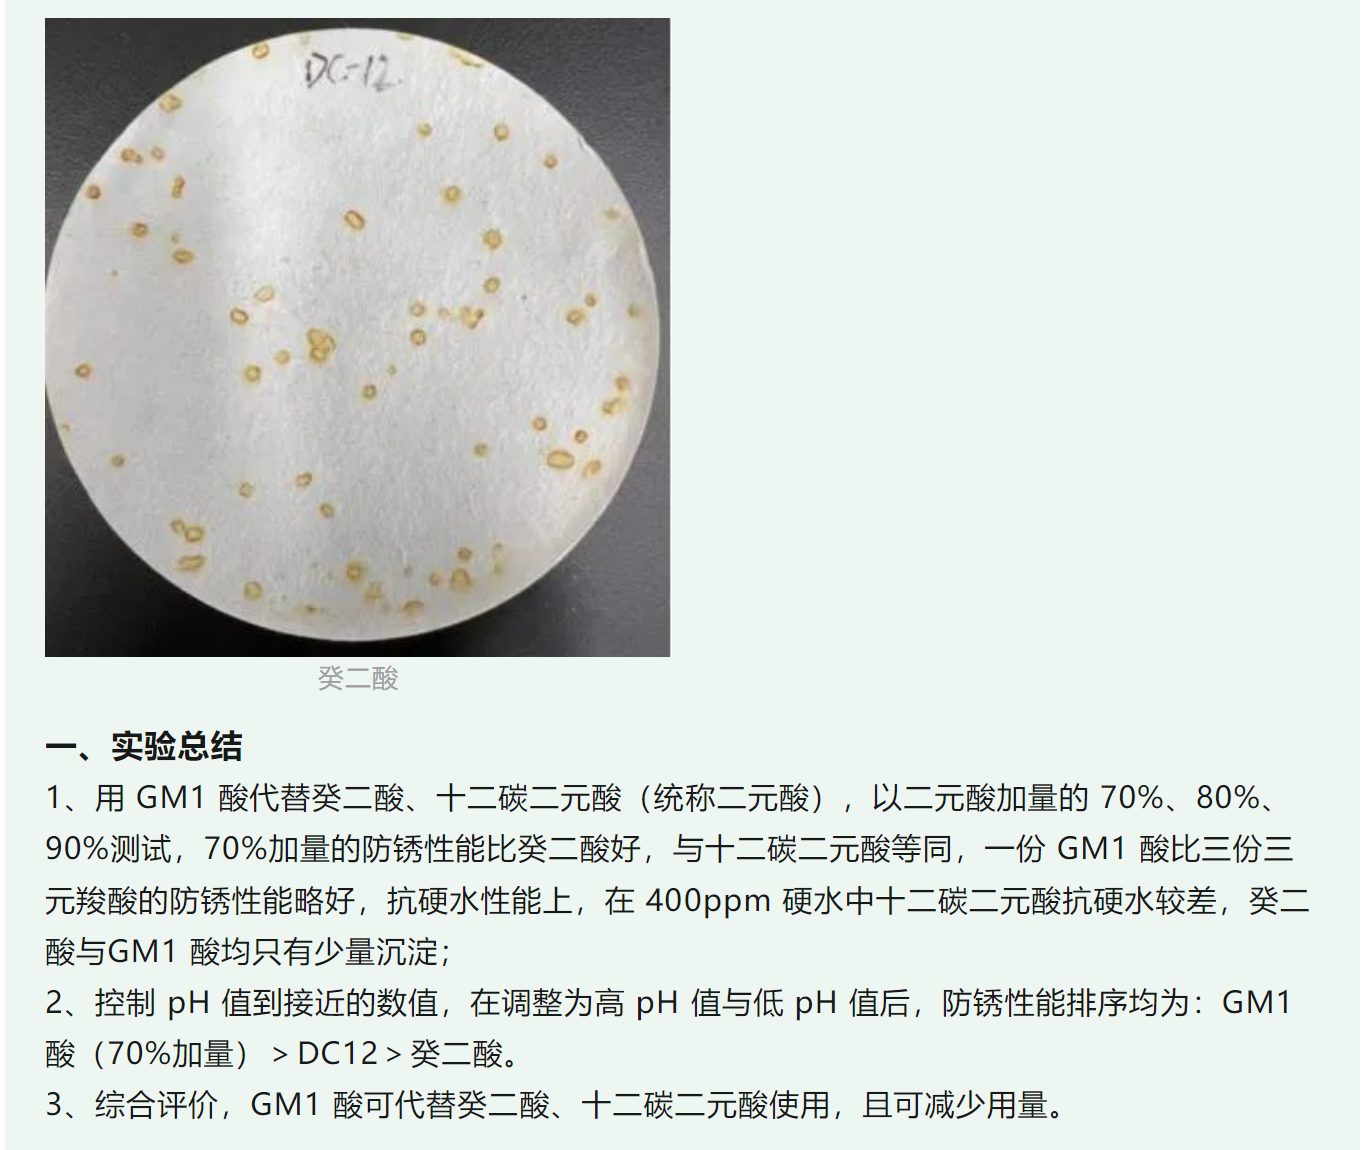

“2024润滑油聚焦年会暨展览展示,第九届中国国际金属加工液及表面清洗技术产业大会”将于2024年9月23-25日在江苏无锡举办!
本次大会为期两天,特邀50+专业嘉宾参与讨论,50+展位展示,800+专业代表参会,主题涵盖金属加工液、工业清洗、表面活性剂、防锈技术、汽车养护等全产业链。大会拓展并深入挖掘润滑油市场的细分产业链,致力于推进发展绿色工业制造业维保新品,构建生态制造体系。
南京古田化工有限公司将出席本次会议,展示企业形象及优质产品。热烈欢迎行业同仁莅临现场,共同交流、讨论和分享经验!
参展企业介绍

南京古田化工有限公司
展位号:B33
古田化工成立于2003年,总部位于南京自有研发团队,设立应用技术开发中心和样品中心,在浙江台州建有100亩生产基地。古田化工在广州设立子公司,在8个城市设有办事处,并成立海外事业部,拓展全球业务;公司自有危化品运输公司能保证安全、便捷的物流服务。
产品介绍

上海国展展览中心有限公司
邮箱:caolina@shanghai-intex.com
电话:021-62952132
邮箱:maomanqi@shanghai-intex.com
电话:021-62955362
更多往届精彩内容可登录展会官网
文章来源:古田化工、阿元
本平台致力于行业分享交流,文章不代表平台观点。文字、图片等版权归原作者所有,如不慎侵权,请致电联系删除。

